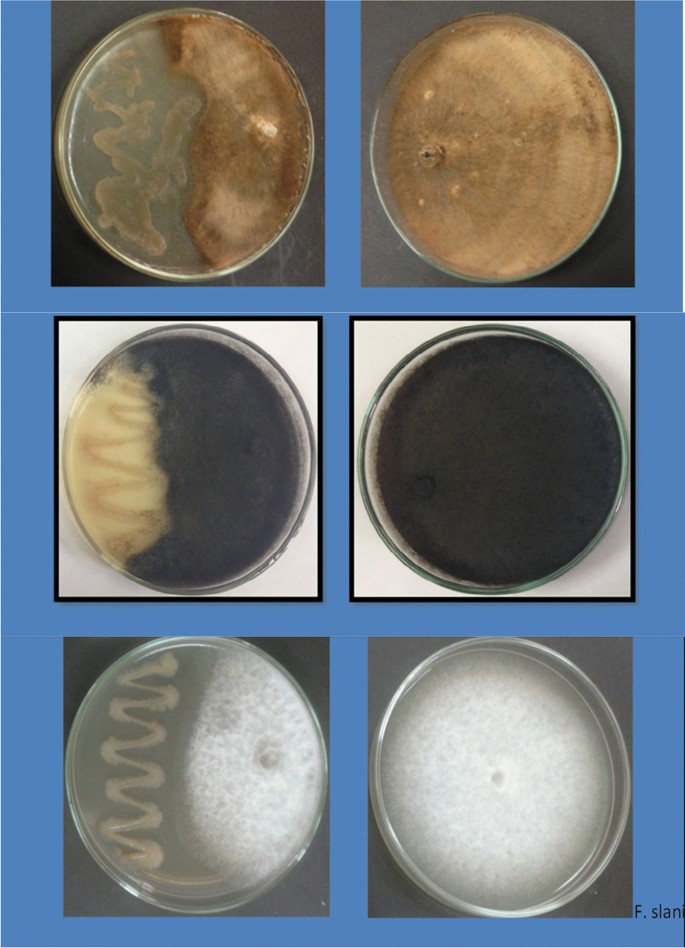

- Research
- Open access
- Published:
Native bacteria for field biocontrol of black root rot in Egyptian strawberry
Bulletin of the National Research Centre volume 46, Article number: 82 (2022)
Abstract
Background
Increasing cultivation of strawberry in Egypt has boosted efforts to increase its yield. Biocontrol agents (BCAs) may avoid side effects and health risks caused by chemical fungicides used to control black root rot disease in strawberry. Some BCAs control the disease and augment strawberry yield, but additional research is needed to fit BCAs into emerging control strategies. The impact of six bacterial isolates of Paenibacillus polymyxa and Bacillus brevis on this disease and on berry yield is reported and compared to a common chemical fungicide.
Results
The bacterial isolates reduced the growth of the black root rot causal agents Fusarium solani, Rhizoctonia solani, and Macrophomina phaseolina, in dual culture bioassays. The greatest fungal inhibition was caused by P. polymyxa isolates 1 and 2 and B. brevis isolate 2. They suppressed the growth of F. solani, R. solani, and M. phaseolina by more than 74, 76, and 79%, respectively. Disease severity and incidence were significantly reduced on naturally infected strawberry plants in the field by the six isolates. The best results were obtained by the superior bioassay isolates which suppressed the disease incidence by 73, 77, and 71%, and its severity by 72, 78, and 70%, respectively. Disease suppression by bacteria was comparable to that by fungicide Actamyl. Bacteria surpassed Actamyl with regard to strawberry yield and enhancement of peroxidase and chitinase activities in the leaves.
Conclusions
These isolates are potential benign alternatives to fungicides used against black root rot in strawberry in Egypt. More studies are needed to examine their economic use on a wider scale.
Background
Strawberry (Fragaria ananassa Duchesne) acreage has been expanding in Egypt due to several merits: the favorable Mediterranean climate, proper fertile soils, and geographic location offering closeness of export markets; all back high yield of a specialty crop. Abd-Elgawad (2019) emphasized that such factors can grant not only good strawberry fruit yield in size and quality with low produce prices but also first fruiting and lengthy reaping season. Admittedly, the ongoing economic crisis associated with corona pandemic enhanced the social and economic gains of the strawberry. The economic significance of the crop is quite apparent, for local consumption (e.g., fresh fruit and juice) and exportation to provide foreign exchange revenue for Egypt. However, the ongoing increase in Egyptian strawberry acreage is frequently accompanied with elevated plant infection by soilborne fungi (El-Shemy et al. 2013; Abd-El-Kareem et al. 2019a, b).
One of the serious and common diseases is the black root rot in Egyptian strawberry acreage. It is brought about by several fungal pathogens (singly or in combination); e.g., Macrophomina phaseolina (Hutton et al. 2013), Fusarium oxysporum (Juber et al. 2014), and Rhizoctonia spp. (Fang et al. 2013). This root disease ranks high among other strawberry rot diseases. A considerable incidence of the disease has been observed in Egypt in recent years (Abd-El-Kareem et al. 2019a). Our field monitoring indicated that Macrophomina phaseolina, Pythium sp. (fungal-like pathogen), Rhizoctonia solani, and Fusarium solani are the primary causal agents of the disease in Egypt. Its quite apparent symptoms are blackening of the main strawberry root resulting in gradual deterioration of the whole plant with decrease in its vitality and productivity. Ultimately, plant death usually occurs via killing and decaying of feeder rootlets (Abdel-Sattar et al. 2008; Fang et al. 2012; Ceja-Torres et al. 2014). Yield increase of 77.1 and 72.8%, was obtained with potassium silicate and calcium silicate, respectively, to control the disease (Abd-El-Kareem et al. 2019a).
Although a few chemical fungicides can sometimes result in reasonable management of fungal diseases, they generally bring about negative impact to the ecological settings and human health. This situation has been sparking researchers to earnestly work to avert the use of toxic fungicides against this serious disease (Abd-El-Kareem et al. 2019a, b, 2021). Biological control is one of the most promising and safe measure in this respect. Biocontrol agents (BCAs) can work through various mechanisms or modes of action (Abd-Elgawad and Askary 2018). Thus, BCAs may offer more durable and fungicidal effect without any toxic/unsafe residues in human food chain (Seddon et al. 2007; Choudhary and Johri 2009; Ahmed 2013). Paenibacillus polymyxa (Bacillales: Paenibacillaceae), the type species of genus, for instance, can be used to control several types of diseases in both horticultural and food crops. It has various benefits comprising promotion of plant growth, nitrogen fixation, solubilizing soil phosphorus, and producing exopolysaccharides, hydrolytic enzymes, antibiotics, and cytokinins (Raza et al. 2008; Lal and Tabacchioni 2009). Seddon et al. (2007) reported that the bacterium Bacillus brevis (Bacillales: Paenibacillaceae) operates against pathogenic fungi of plant via two mechanisms. Firstly, the gramicidin S as antifungal metabolite can directly suppress conidial evolution/growth of the pathogen. The second mechanism is through the bio-surfactant manufactured by B. brevis. It can lower surface wetness in events where saturation of relative humidity is not prevailed. Thus, the fungal conidia cannot germinate.
The objective of the present investigation was to evaluate the impacts of soil treatments with three isolates for each of Paenibacillus polymyxa and Bacillus brevis on strawberry black root rot disease and crop yield parameters. Putative enzymatic activities related to the presumed effects were measured.
Methods
Black root rot disease-causal fungi and their tested antagonists
Local isolates of the pathogenic fungi Macrophomina phaseolina, F. solani, and R. solani, the causal agents of this disease on strawberry roots and 3 isolates for each of Bacillus brevis and Paenibacillus polymyxa as antagonistic bacteria are maintained and supplied by Plant Pathology Department, National Research Centre (NRC) Giza, Egypt, for this study. These fungi and their antagonists were originally isolated from strawberry fields, Eldeer village, Qalioubia Governorate during previous experimentation (Abd-El-Kareem et al. 2019a, b; unpublished data). Among 67 isolates, we selected only six bacterial antagonists with the highest effectiveness against the pathogenic fungi. This research is a series of experiments on the use of biocontrol agents in controlling black root rot disease in strawberry plants. More details on the identification of these biologicals are given as a Additional file 1.
Bioassays of the bacterial isolates against the pathogens
The P. polymyxa isolates 1, 2, and 3 and B. brevis isolates 1, 2, and 3 were tested against the black root rot pathogens M. phaseolina, R. solani, and F. solani via the dual culturing as set out by Estrella et al. (2007). Each bacterial isolate was singly cultured at 1 cm from the edge of a Petri plate. It was streaked on fresh and sterilized potato dextrose agar (PDA) medium in the plate. Five 9-cm diameter Petri plates with the medium were used as replicates per treatment (a fungal species) and the untreated check. Suppressing the growth of the fungal mycelium was then estimated using Pandey et al. (2000)’s formula as follows:
where R = growth reduction of the fungal mycelium (%), C = radius (cm) of growth of the fungal isolate in control dishes, and T = radius (cm) of growth of the fungal isolate in dual culture dishes.
Field trials
Field trials were conducted during 2019/20 and 2020/21 growing seasons (mid-October to end of April) at Qalioubia Governorate (Eldeer village, Toukh), Egypt, with light loamy soil and natural infestation. This field has a history of soil infested by the black root rot disease (Abd-El-Kareem et al. 2019a, b, 2021). Three plots (each of 1.2 × 5 m) were replicated for each treatment including each of the bacterial isolate and the fungicide Actamyl (3 g/l as recommended by manufacturer) in addition to the untreated check. A replicate contained 100 strawberry transplants. Seedlings of the cultivar Festival were dipped in bacterial cell suspension [1 × 108 colony forming units (CFU)/ml water per a bacterial isolate] for 30 min (Abd-El-Kareem et al. 2019b) then mingled with 5% Arabic gum to boost glutinous capacity and attain sound distribution of the bacteria on the surfaces of the addressed roots immediately pre-transplanting. Only water was used for soaking seedlings for the same term to act as the control. The experimental layout was a completely randomized block model. All strawberry transplants had the same production practices of fertilizers, irrigation, and fruit collection plan (El-Shemy et al. 2013).
Rating disease incidence and severity
Disease incidence was rated 100 days after cultivation as follows:
Disease severity (DS) was computed at the season-end (6.5 months after transplanting) using the following 0–5 rate set out by Morocko (2006):
Determination of plant growth parameters and yield
Strawberry plant weights (fresh and dry) in each treatment were recorded at season end. Also, assembled fruit yield (Ton/feddan) in each treatment was estimated at season-end.
Enzyme activities in strawberry leaves
Extraction of enzymes
Fresh strawberry leaves (g) were collected and homogenized according to Abd-El-Kareem et al. (2019a, b). A 0.1 M sodium phosphate buffer (pH 7.1) at the rate of 1/3 w/v (Goldschmidt et al. 1968) was used. The resultant material was subjected to centrifugation at 3000 rpm for 15 min, and the activities of the following enzymes were assessed in the supernatant. Three replicates for each treatment were used.
Peroxidase
Its activity was measured as set out by Abeles et al. (1971), and 0.1 ml of the enzyme extract was incubated with 4 ml of guaiacol solution for 1 min at 25 °C and absorbance at 470 nm. The solution of guaiacol comprised 0.5 ml of 2% guaiacol, 3 ml of 0.05 M potassium phosphate, pH 7, and 0.5 ml of 0.3% H2O2. The enzyme activity was shown as the increment in absorbance at 470 nm/gram fresh weight/1 min using spectrophotometer (Spectronic 20-D).
Chitinase
Chitin powder was used to prepare the substrate colloidal chitin (Ried and Ogryd-Ziak 1981). Monreal and Reese (1969)’s method was applied to determine the chitinase activity.
Reducing sugar was assessed in 1 ml of the supernatant by dinitrosalicylic acid. The optical density was determined at 540 nm using spectrophotometer (Spectronic 20-D). The enzyme activity was explained in terms of mM N-acetylglucosamine equivalent released/gram fresh weight tissue/60 min.
Statistical analysis
Analysis of variance (ANOVA) was applied on the bioassay of the growth areas for the tested fungi using dual culturing and on the combined treatments of the two seasons. Means were separated via Duncan’s New Multiple Range Test (DNMRT).
Results
The antagonistic bacterial effect on the fungal growth
All the tested isolates of B. brevis and P. polymyxa differently decreased the growth area of F. solani, R. solani, and M. phaseolina (Table 1). The highest reduction was obtained with P. polymyxa isolates 1 and 2 and B. brevis isolate 2 which reduced the growth area by more than 74.4, 76.4 and 79.6% for F. solani, R. solani, and M. phaseolina, respectively. Moderate reduction was brought about by the other isolates. Examples are illustrated to demonstrate the reduction caused by Bacillus brevis isolate 2 (Fig. 1) and P. polymyxa isolate 1 (Fig. 2).
Field bacterial effects
The six isolates of P. polymyxa and B. brevis were tested for their impact on black root rot disease, strawberry vegetative characters, and yield as well as enzyme activities of strawberry plants under field conditions.
Their impacts on the strawberry disease
All the tested isolates of P. polymyxa and B. brevis considerably reduced the black root rot disease incidence and severity on strawberry plants (Table 2). Less plant intensity with more dead or unhealthy plants was found in the untreated control plots (Fig. 3). The best plant growth was found in plots treated with P. polymyxa isolates 1 and 2 and B. brevis isolate 2. The latter 3 isolates could reduce the disease incidence by 73.1, 76.9 and 71.2% and disease severity by 72, 78, and 70%. Meanwhile, the other isolates showed moderate bacterial impact. The reduction in disease incidence and severity obtained by P. polymyxa isolates 1 and 2 and B. brevis isolate 2 was not different (P ≤ 0.05) from that scored by the fungicide Actamyl (Table 2).
Their impacts on strawberry growth
All the tested isolates of P. polymyxa and B. brevis considerably boosted fresh and dry weight of strawberry plants (Table 3). The highest increase was recorded by P. polymyxa isolates 1 and 2 which elevated fresh weight by 100 and 103% and dry weight by 112 and 106%, respectively. Meanwhile, the other isolates had less favorable effects.
Their impacts on strawberry yield
All the tested isolates of B. brevis and P. polymyxa significantly enhanced strawberry yield (Table 4). The highest increase was obtained by P. polymyxa isolates 1 and 2 and B. brevis isolate 2 which raised strawberry yield by 78.9, 84.2, and 68.4%, respectively. Meanwhile, other isolates showed moderate positive impacts. The superior isolates, P. polymyxa isolates 1 and 2 and B. brevis isolate 2, surpassed Actamyl in boosting the strawberry yield.
Their impacts on enzyme activities of strawberry plants
All the tested isolates of P. polymyxa and B. brevis significantly increased enzyme activity of strawberry plants (Table 5). The highest activities were caused by P. polymyxa isolates 1 and 2 and B. brevis isolate 2 which elevated peroxidase activity by 130, 145, and 140% and chitinase activity by 133.3, 140, and 68.4%, respectively. The other isolates showed moderate impact on the activities of the two enzymes (Table 5).
Discussion
The averages of strawberry plant weight and fruit yield of the two combined growing seasons were variably enhanced due to application of each bacterial isolate tested. Such increases were probably resulting from suppression of the fungal pathogens causing the root rot disease. This was evidenced by the big reduction in the growth area of the causal fungi, and the severity and incidence of the disease. Some strains of P. polymyxa are known to produce antibiotics as polymyxins and fusaricidin (Mahajan and Balachandran 2017; Shaheen et al. 2011) while those of B. brevis produce antibiotics as tyrocidine and gramicidin (Mohamed 2020). Superior isolates that brought about the best reduction and greatest yield were P. polymyxa 1 and 2 as well as B. brevis 2. Interestingly, these three isolates demonstrated notable reduction in disease incidence and severity comparable to the chemical fungicide Actamyl. This fungicide is effective and of common use (Abd-Elsayed et al. 2019; Abd El-Razek et al. 2021) as well as recommended by the Egyptian Ministry of Agriculture (Agricultural Pesticides Committee 2020). However, stakeholders should be aware of the development of the chemical fungicide resistance as it is impacted by multiple factors, e.g., its mode of action and use pattern, the biology of the targeted pathogen, and the cropping system.
Hence, these benign isolates can be tried in earnest as safe alternatives to the relevant chemicals that are commonly used against this disease. The use of chemical fungicides can result in numerous undesirable effects, comprising (1) side-effects on beneficial and non-targeted fungi; (2) outbreaks/resurgence of secondary pathogens pests; (3) development of fungicide resistance; (4) contamination/pollution of the ecological settings/wildlife ecosystem; (5) gradual gathering of fungicide residues in food stuffs/materials; (6) lack of harmony in beneficial processes, e.g., pollination as pollinators are adversely affected; and (7) human diseases such as carcinogenic impacts (Kumar et al. 2021; Liu et al. 2021).
Additionally, BCAs related to species of Bacillus work through different modes of action. This helps them to be both more effective and durable without any toxic residues in the human food chain (Choudhary and Johri 2009; Ahmed 2013). The three superior isolates were also the best in increasing peroxidase and chitinase activities which imply plant resistance against diseases as these enzymes are pathogenesis-related proteins in strawberry plants. Although plant resistance is activated by the BCAs (increased chitinase and peroxidase plant activities), the same was fairly demonstrated in the case of Actamyl which also elevated those enzymes to a lesser degree. That is possibly because plant defense system has different levels of specialization. A first or basic level induces a general innate defense. This basic level might slightly increase those enzymes but usually specialized pathogens overcome this defense level (Molinari 2020).
Moreover, Paenibacillus polymyxa has various advantages comprising nitrogen fixation, promotion of plant growth, solubilization of soil phosphorus, and production of exopolysaccharides, hydrolytic enzymes, antibiotics, and cytokinins (Lal and Tabacchioni 2009). Paenibacillus polymyxa can produce antibiotics that are so effective in controlling plant pathogens (Raza et al. 2008).
Many researchers have focused on biocontrol as a promising alternative for managing soil-borne diseases in sustainable and organic agriculture including integrated pest management (IPM). Their results revealed that a number of bacteria such as Pseudomonas spp. (Oktay and Kemal 2010), Bacillus spp. (Mansoori et al. 2013) and Streptomyces spp. (Xue et al. 2016) were able to outstandingly reduce plant diseases. More recently, studies have indicated that the plant growth-promoting rhizobacteria (PGPR) may also suppress different plant diseases (Remans et al. 2008; Rocheli et al. 2015). Among them, endospore-forming PGPRs, especially gram-positive Paenibacillus polymyxa and Streptomycetes, have better results than non-PGPRs due to being resistant to heat, radiation, drying, and toxic chemicals (Comasriu and Vivesrego 2002). These PGPR can produce a variety of antibiotics often associated with the ability of the bacterium to prevent proliferation of plant pathogens. Also, a number of PGPRs can generate enzymes such as proteases, chitinases, glucanases, and lipases that can lyse a portion of the cell walls of many pathogenic fungi (Majeed et al. 2015). The mechanisms by which these BCAs suppress many types of pathogens and pests differ among species/strains and therefore can be used in IPM (Dey et al. 2004; Lucy et al. 2004; Remans et al. 2008; Abd-Elgawad 2021a, b).
The bacterium Bacillus brevis operates as BCA against fungal plant pathogens via the two aforementioned modes of action. These mechanisms and their contribution to disease control were established and confirmed using wild-type and a gramicidin S-negative mutant of B. brevis (Seddon et al. 2007). Target crops were tomato, lettuce and cucumber. Cultures of B. brevis, fractionated into spore and supernatant fractions showed that disease control was due to gramicidin S and/or biosurfactant. Hence, disease control may vary due to the plant species and the prevailing ecological conditions.
Conclusions
Although six isolates of Paenibacillus polymyxa and Bacillus brevis tested herein proved to be safe and effective on strawberry black root rot disease, three isolates (P. polymyxa isolates 1 and 2 as well as B. brevis isolate 2) caused the best control. They inhibited the pathogen growth by more than 74, 76, and 79% for F. solani, R. solani, and M. phaseolina, respectively. Future research to use either of them singly or in combinations with a complementary disease control material(s) such as a plant extract should be attempted in earnest, especially in IPM programs.
Availability of data and materials
The datasets used and/or analyzed during the current study are available from the corresponding author on reasonable request.
Abbreviations
- ANOVA:
-
Analysis of variance
- BCAs:
-
Biological control agents
- DNMRT:
-
Duncan’s new multiple range test
- IPM:
-
Integrated pest management
- PDA:
-
Potato dextrose agar
- PGPR:
-
Plant growth-promoting rhizobacteria
References
Abd El-Razek EA, Rizk MA, Abdallah Y, Abou-Taleb KA, Abdelmegeed SM (2021) Effect of fungicide, salicylic acid, henna powder and propolis on silkworm larvae infected with Aspergillus spp. Arab Univ J Agric Sci Ain Shams Univ 29(2):775–786
Abd-Elgawad MMM (2019) Plant-parasitic nematodes of Strawberry in Egypt: a review. Bull NRC 43:7. https://doi.org/10.1186/s42269-019-0049-2
Abd-Elgawad MMM (2021a) Optimizing safe approaches to manage plant-parasitic nematodes. Plants 10:1911. https://doi.org/10.3390/plants10091911
Abd-Elgawad MMM (2021b) Photorhabdus spp.: an overview of the beneficial aspects of mutualistic bacteria of insecticidal nematodes. Plants 10:1660. https://doi.org/10.3390/plants10081660
Abd-Elgawad MMM, Askary TH (2018) Fungal and bacterial nematicides in integrated nematode management strategies. Egypt J Biol Pest Control 28:74. https://doi.org/10.1186/s41938-018-0080-x
Abd-El-Kareem F, Elshahawy IE, Abd-Elgawad MMM (2019a) Effectiveness of silicon and silicate salts for controlling black root rot and induced pathogenesis-related protein of strawberry plants. Bull NRC 43:91. https://doi.org/10.1186/s42269-019-0139-1
Abd-El-Kareem F, Elshahawy IE, Abd-Elgawad MMM (2019b) Local Trichoderma strains as a control strategy of complex black root rot disease of strawberry in Egypt. Bull NRC 43:160. https://doi.org/10.1186/s42269-019-0206-7
Abd-El-Kareem F, Elshahawy IE, Abd-Elgawad MMM (2021) Application of Bacillus pumilus isolates for management of black rot disease in strawberry. Egypt J Biol Pest Control 31:25. https://doi.org/10.1186/s41938-021-00371-z
Abd-Elsayed MHF, Sarhan EAD, Ebrahiem AMY (2019) Management of cucumber powdery mildew disease caused by Podosphaera xanthii by some fungicides and resistance inducing chemicals. Curr Sci Int 8(4):820–828
Abdel-Sattar MA, El-Marzoky HA, Mohamed AI (2008) Occurrence of soilborne diseases and root knot nematodes in strawberry plants grown on compacted rice straw bales compared with naturally infested soil. J Plant Prot Res 48(2):223–235
Abeles FB, Bosshart RP, Forrence LE, Habig WH (1971) Preparation and purification of glucanase and chitinase from bean leaves. Plant Physiol 47:129–134
Agricultural Pesticides Committee (2020) Adopted recommendations to control agricultural pests. Agricultural Pesticides Committee, Ministry of Agriculture and Land Reclamation, Commercial Al-Ahram Press, Qalioub
Ahmed MFA (2013) Studies on non-chemical methods to control some soil borne fungal diseases of bean plants Phaseolus vulgaris L. Ph.D. thesis, Faculty of Agriculture, Cairo Univ., pp 137
Ceja-Torres LF, Mora-Aguilera G, Mora-Aguilera A (2014) Agronomical management influence on the spatiotemporal progress of strawberry dry wilt in Michoacán, Mexico. Afr J Agric Res 9(4):513–520
Choudhary DK, Johri BN (2009) Interaction of Bacillus spp. and plants with special reference to induced systemic resistance. Microbiol Res 164:493–513
Comasriu J, Vivesrego J (2002) Cytometric monitoring of growth, sporogenesis and spore cell sorting in Paenibacillus polymyxa (formerly Bacillus polymyxa). J Appl Microbiol 92:475–481
Dey R, Pal KK, Bhatt DM, Chauhan SM (2004) Growth promotion and yield enhancement of peanut (Arachis hypogaea L.) plant growth-promoting rhizobacteria. Microbiol Res 159:371–394
El-Shemy AA, Khafagy YS, Al-Genteery AMM (2013) Cultivation and production of strawberry. Cairo: Tech issue no. 9/2013, General Directorate of Agricultural Culture. Egypt Minist Agric (in Arabic)
Estrella FS, Vargas GC, Lopez MJ, Moreno J (2007) Antagonistic activity of bacteria and fungi from horticultural compost against Fusarium oxysporum f. sp.melonis. Crop Prot 26:46–53
Fang XD, Kuo J, You MP, Finnegan PM, Barbetti MJ (2012) Comparative root colonization of strawberry cultivars Camarosa and Festival by Fusarium oxysporum f. sp. fragariae. Plant Soil 358:75–89
Fang XD, Finnegan MP, Barbetti MJ (2013) Wide variation in virulence and genetic diversity of binucleate Rhizoctonia isolates associated with root rot of strawberry in western Australia. PLoS ONE 8(2):e55877
Goldschmidt EE, Goren R, Monselise SP (1968) The indol acetic acid oxidase system of citrus roots. Planta 72:213–222
Hutton DG, Gomez AO, Mattner SW (2013) Macrophomina phaseolina and its association with strawberry crown rot in Australia. Int J Fruit Sci 13(1–2):149–155
Juber KS, Al-Juboory HH, Al-Juboory SB (2014) Fusarium wilt disease of strawberry caused by Fusarium oxysporum f. sp. Fragariae in Iraq and its control. J Exp Biol Agric Sci 2(4):419–427
Kumar J, Ramlal A, Mallick D, Mishra V (2021) An overview of some biopesticides and their importance in plant protection for commercial acceptance. Plants 10:1185. https://doi.org/10.3390/plants10061185
Lal S, Tabacchioni S (2009) Ecology and biotechnological potential of Paenibacillus polymyxa: a minireview. Indian J Microbiol 49:2–10
Liu X, Cao A, Yan D, Ouyang C, Wang Q, Li Y (2021) Overview of mechanisms and uses of biopesticides. Int J Pest Manag 67:65–72
Lucy M, Reed E, Glick BR (2004) Applications of free living plant growth-promoting rhizobacteria. Anton Leeuw 86:1–25
Mahajan GB, Balachandran L (2017) Sources of antibiotics: hot springs. Biochem Pharmacol 134:35–41
Majeed A, Abbasi MK, Hameed S, Imran A, Rahim N (2015) Isolation and characterization of plant growth-promoting rhizobacteria from wheat rhizosphere and their effect on plant growth promotion. Front Microbiol 6:198
Mansoori M, Heydari A, Hassanzadeh N, Rezaee S, Naraghi L (2013) Evaluation of Pseudomonas and Bacillus bacterial antagonists for biological control of cotton Verticillium wilt disease. J Plant Prot Res 53:154–157
Mohamed F (2020) Enhancement of β-cyclodextrin production and fabrication of edible antimicrobial films incorporated with clove essential oil/β-cyclodextrin inclusion complex. Microbiol Biotechnol Lett 48(1):12–16
Molinari S (2020) Can the plant immune system be activated against animal parasites such as nematodes? Nematology 22:481–492
Monreal J, Reese ET (1969) The chitinase of Serratia marcescens. Can J Microbiol 15:689–696
Morocko I (2006) Characterization of the strawberry pathogen Gnomonia fragariae, and biocontrol possibilities. Ph.D. dissertation. ISSN 1652–6880, ISBN 91–576–7120–6
Oktay E, Kemal B (2010) Biological control of Verticillium wilt on cotton by the use of fluorescent Pseudomonas spp. under field conditions. Biol Control 53:39–45
Pandey KK, Pandey PK, Upadhyay JP (2000) Selection of potential isolate of biocontrol agents based on biomass production, growth rate and antagonistic capability. Veg Sci 27:194–196
Raza W, Yang W, Shen QR (2008) Paenibacillus polymyxa: antibiotics, hydrolytic enzymes and hazard assessment. J Plant Pathol 90:419–430
Remans R, Beebe S, Blair M, Manrique G, Tovar E, Rao I, Croonenborghs A, Torres-Gutierrez R, El-Howeity M, Michiels J (2008) Physiological and genetic analysis of root responsiveness to auxin-producing plant growth-promoting bacteria in common bean (Phaseolus vulgaris L.). Plant Soil 302:149–161
Ried JD, Ogryd-Ziak DM (1981) Chitinase over producing mutant of Servatia marcescens. Appl Environ Microbiol 41:664–669
Rocheli DS, Adriana A, Passaglia LMP (2015) Plant growth-promoting bacteria as inoculants in agricultural soils. Genet Mol Biol 38:401–419
Seddon B, McHugh RC, Schmitt A, Koch E, Graham N, Wilson M, Eibel P (2007) Disease control with Bacillus brevis: update and future prospects. In: Dehne HW, Deising HB, Gisi U, Kuck KH, Russell PE, Lyr H (eds) Modern fungicides and antifungal compounds V: 15th international reinhardsbrunn symposium, May 6–10, 2007. Friedrichroda, Germany
Shaheen M, Li J, Ross AC, Vederas JC, Jensen SE (2011) Paenibacillus polymyxa PKB1 produces variants of polymyxin B-type antibiotics. Chem Biol 18(12):1640–1648
Xue L, Gu MY, Xu WL, Lu JJ, Xue QH (2016) Antagonistic streptomyces enhances defense-related responses in cotton for biocontrol of wilt caused by phytotoxin of Verticillium dahliae. Phytoparasitica 44(2):225–237
Acknowledgements
The authors acknowledge the financial support in part of this study by the US-Egypt Project cycle 17 (no. 172) entitled “Preparing and evaluating IPM tactics for increasing strawberry and citrus production.” This article is derived from the Subject Data funded in part by NAS and USAID, and that any opinions, findings, conclusions, or recommendations expressed in it are those of the authors alone and do not necessarily reflect the views of USAID or NAS. The facilities offered by The National Research Centre are appreciated. Thanks to Prof. Dr. Larry W. Duncan, University of Florida, USA, for revising parts of the manuscript.
Funding
Financial support was partially made by both US-Egypt Project related to Science and Technology Development Fund via Project cycle 17 (no. 172) and National Research Centre, Egypt, to develop and analyze the data.
Author information
Authors and Affiliations
Contributions
All authors equally participated in the development and implementation of the reviewing plan. Subsequently, they worked it out wrote the manuscript; the first author FA wrote and discussed the different parts of the article with IE and MA and all together finalized the manuscript. All authors have read and approved the final manuscript.
Corresponding author
Ethics declarations
Ethics approval and consent to participate
Not applicable.
Consent for publication
Not applicable.
Competing interests
The authors declare that they have no competing interests.
Additional information
Publisher's Note
Springer Nature remains neutral with regard to jurisdictional claims in published maps and institutional affiliations.
Supplementary Information
Additional file 1
. Identification of the examined organisms.
Rights and permissions
Open Access This article is licensed under a Creative Commons Attribution 4.0 International License, which permits use, sharing, adaptation, distribution and reproduction in any medium or format, as long as you give appropriate credit to the original author(s) and the source, provide a link to the Creative Commons licence, and indicate if changes were made. The images or other third party material in this article are included in the article's Creative Commons licence, unless indicated otherwise in a credit line to the material. If material is not included in the article's Creative Commons licence and your intended use is not permitted by statutory regulation or exceeds the permitted use, you will need to obtain permission directly from the copyright holder. To view a copy of this licence, visit http://creativecommons.org/licenses/by/4.0/.
About this article
Cite this article
Abd-El-Kareem, F., Elshahawy, I.E. & Abd-Elgawad, M.M.M. Native bacteria for field biocontrol of black root rot in Egyptian strawberry. Bull Natl Res Cent 46, 82 (2022). https://doi.org/10.1186/s42269-022-00775-3
Received:
Accepted:
Published:
DOI: https://doi.org/10.1186/s42269-022-00775-3